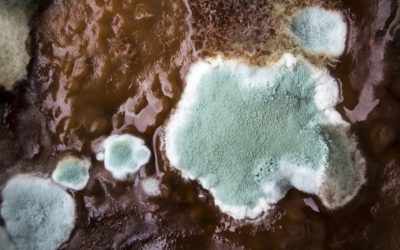
Health Issues? Reduce the Risk – Why You May Need A Hoarding Clean Up Service

The world of crime scene, hoarding and suicide cleaning services has recently been glamourised by TV shows which do not unfortunately portray an accurate picture of the industry. Extreme cleaners or ‘trauma cleaners’ as we prefer to refer to them, are hardworking,...
Trauma Clean 24 Seven
Emergency Cleaning – A Clean Up After Death
No one should be tasked with the awful situation of organising the emergency cleaning service required when a friend or family member has passed away unattended in the home. When a bereavement happens it is a very emotional and tragic time for everyone involved. In...
Is Mould in the Home a Biohazard?
Mould growing inside your home can have a serious effect on occupants. If you already suffer from respiratory problems such as infections, allergies or asthma mould inside the home can exacerbate this. Some people are more sensitive to the effects of mould in the...
How the Trauma Clean 24 Seven Team Work
The world of crime scene, hoarding and suicide cleaning services has recently been glamourised by TV shows which do not unfortunately portray an accurate picture of the industry. Extreme cleaners or ‘trauma cleaners’ as we prefer to refer to them, are hardworking,...
Flood and Sewage Clean Up – Beating the Thaw
We have already been very busy here at Trauma Clean 24 Seven with calls from flooded properties – many businesses and domestic properties are suffering from burst pipes due to the thaw following the recent cold snap. There are ways in which you can protect yourself...
Clean Up After Death or a Trauma & Crime Scene Cleaning Service
When a traumatic death or crime occurs at a property, it is the owner’s responsibility to ensure that the setting is cleaned and sanitised. Unfortunately for families who have lost a loved one, this suggests the onus is on them to take on the job themselves....
Biohazards in the Home – Hoarding Clean Up or Declutter Service
Do you know what a biohazard is? Many people have a limited knowledge when it comes to identifying biohazards in the home. Some biohazards can be found in every day life and others are sadly a result of a death in the family or a traumatic event. Some can be the...
Biohazard Clean Up After Death or Illness
Our operatives work hard to bring a professional and friendly clean up after death service to families who have lost a loved one. Alternatively, our biohazard declutter and hoarding clean up service is available if you have a relative who has been unwell; if blood,...
Health Issues? Reduce the Risk – Why You May Need A Hoarding Clean Up Service
Every time we breathe, we inhale a cocktail of potential pathogens. And we inhale about 20 times a minute, nearly 30,000 times a day, sucking in 15,000 litres of air. The world we live in is saturated with potential pathogens. Our bodies are designed to protect us...